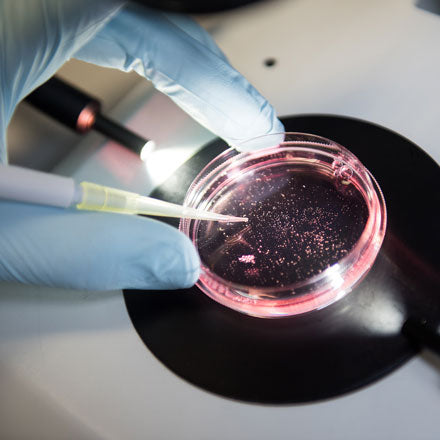
Add a £5 donation to Breakthrough T1D

Add a £5 donation to Breakthrough T1D
Add a donation to your order this Christmas and help support Breakthrough T1D's cutting-edge research to treat, prevent and cure type 1 diabetes
Add a donation to your order this Christmas and help support Breakthrough T1D's cutting-edge research to treat, prevent and cure type 1 diabetes